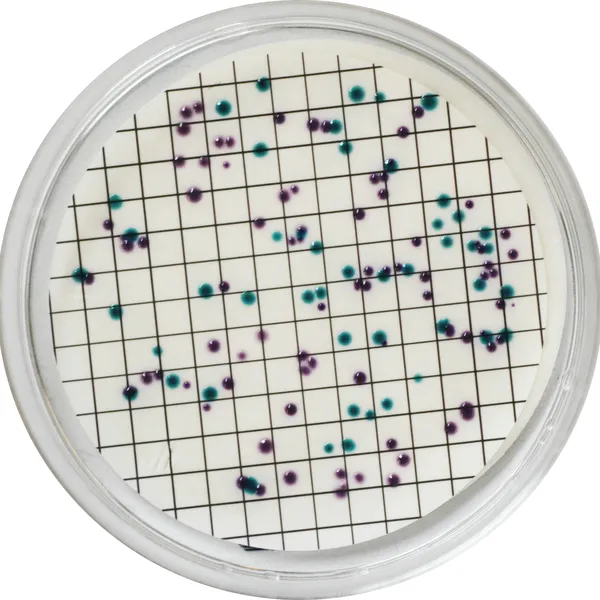
CHROMagar™ Liquid ECC

Colonies Appearance

E. coli
blue

Others coliforms
purple
Performance
Performance
Strict regulations exist for E. coli/coliform presence in water samples. This can be explained by the importance of these germs in determining water and food safety. Worldwide, water and food quality control for human consumption are based on detecting and numerating E. coli and coliforms.
Coliforms, Enterobacteriacae able to ferment lactose, are bacteria present in human and warm-blooded animal intestinal flora, in the soil and water. Coliforms are proof of organic, environmental or faecal contamination. Faecal contamination, due to colifoms coming from animal waste, consists mainly of Escherichia coli and thermotolerant Klebsiella.
E. coli can contaminate drinking water when the water treatment system is inadequate or during periods of very high rainfalls. Monitoring of food and water production is essential. High contamination may lead to suspension of the water supply and food recall by supermarkets.
In the U.S.A. the EPA recommendations through the Total Coliform Rule (TRC) are:
• <1 000 CFU/100 mL for a fishing and boating water quality.
• <100 CFU/100 mL for a body-contact recreation water quality.
• <1 CFU/100 mL for a drinking water quality.
1. Simplicity: Very easy to prepare compared to agar based culture media.
4. Easy to read thanks to high colony colour contrast: There is no mixing of both colours (contrary to other chromogenic media on the market). Colonies are either purple or blue.
2. Economic: only 2 mL/test (instead of the 10-20 mL for the other culture media).
3. Easy method: CHROMagar™ Liquid ECC allows a simultaneous detection and differentiation between E. coli and coliforms in one medium. This is helpful to determine if there is organic contamination (coliforms) or faecal contamination (E. coli). The use of this technique involves less work in comparison with traditional methods (MI Agar).
Composition

Technical Documents
Scientific Publications
1997
Enumeration of E. coli in environmental waters and wastewater using a chromogenic medium
📄 Publication1995
A Comparative Study of Selective Media Used to Detect and Confirm Coliforms and Escherichia coli in Water Samples Using Membrane Filtration
📄 Publication

Read more